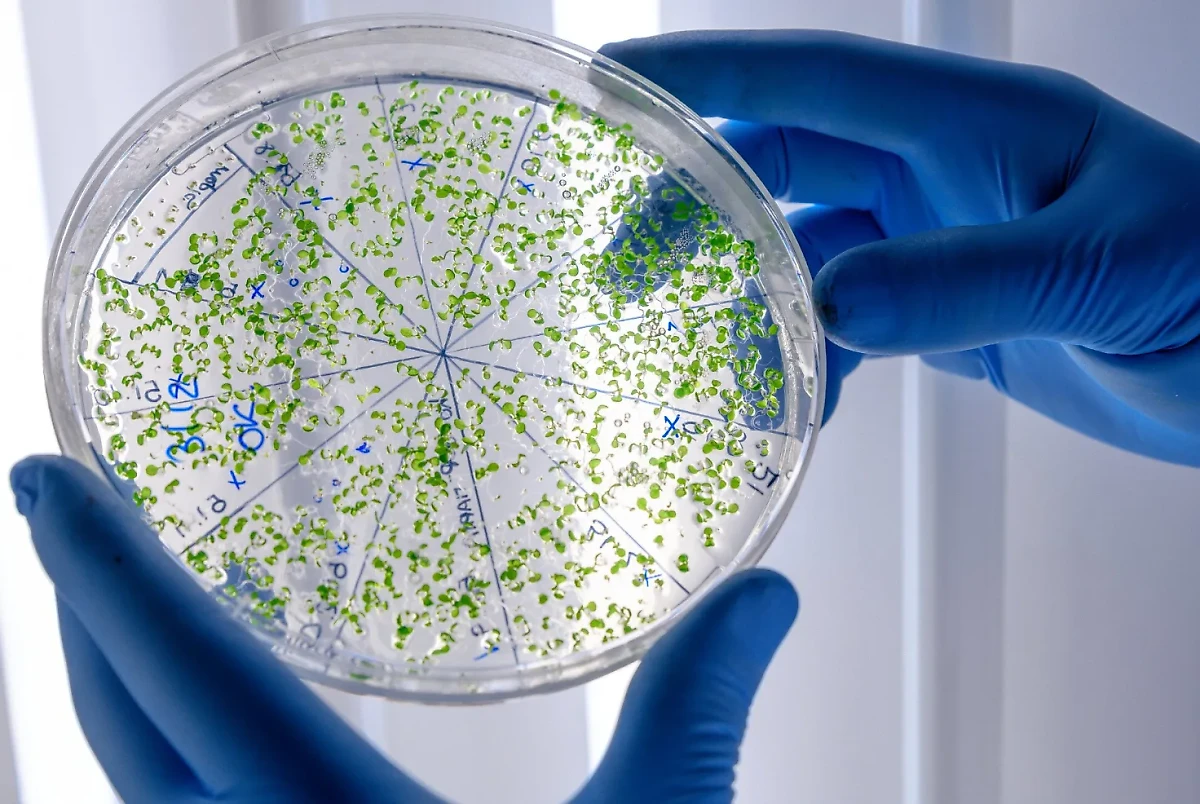
Бактерии, стойкие к антибиотикам, к 2050 году могут убить более 39 миллионов человек. Обложка © freepik.com/wirestock

Инфекционист объяснила, чем опасны супербактерии, которые могут убить 39 млн человек к 2050 году
Врач Мескина: Супербактерии вырабатывают резистентность ко всем антибиотикам
Бактерии, стойкие к антибиотикам, к 2050 году могут убить более 39 миллионов человек. Обложка © freepik.com/wirestock
Появление супербактерий, которые к 2050 году могут убить более 39 миллионов человек, вызвано нерациональным использованием антибиотиков. Об этом Life.ru рассказала врач-инфекционист Елена Мескина, комментируя прогноз ВОЗ по смертности от этих бактерий.

Начнём с того, почему их называют супербактериями. Они вырабатывают резистентность ко всем антибиотикам, которые существуют на сегодняшний день. Наиболее опасны эти инфекции для людей, которые находятся в критическом состоянии, в реанимации, в хирургии, в ожоговых центрах, недоношенные, больные дети. У таких пациентов не хватает резервных возможностей организма для того, чтобы справляться с этой инфекцией.

Основная причина появления таких бактерий – нерациональное использование антибиотиков, причём не только в медицине, но даже животноводстве. Всё это приводит к тому, что бактерии вырабатывают «оружие» против препаратов и разрушают антибиотики при помощи выработки специальных ферментов.
«Здоровые люди распространяют имеющиеся у них супербактерии не болея, а вот те, у кого хронические заболевания, кто лежит в реанимации, могут быть подвержены и летальному исходу», — предупредила врач.
Чтобы избежать негативного прогноза ВОЗ, Мескина считает необходимым полностью менять стратегию лечения населения, также важно понимать, что пить антибиотики при любом удобном случае нельзя.
Напомним, ранее эксперты ВОЗ сделали страшный прогноз о том, что бактерии, стойкие к антибиотикам, к 2050 году могут убить более 39 миллионов человек. К середине века смертность по этой причине увеличится вдвое. Для предотвращения такого сценария учёные призывают срочно разработать новые стратегии по предотвращению развития инфекций.


